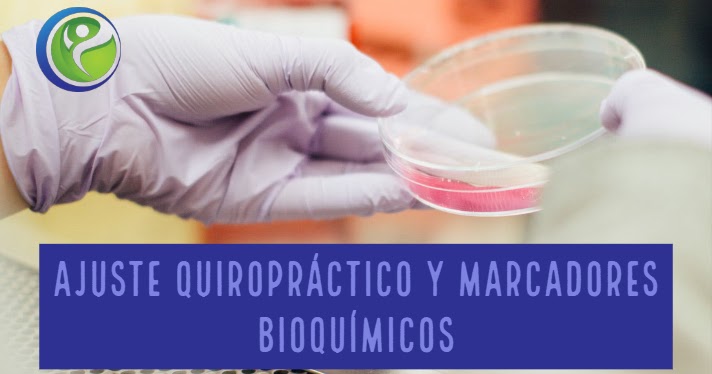

Para el blog entero: https://quiropracticaymas.blogspot.com
Estrés Crónico
Usamos la palabra “estrés” a menudo en la vida diaria ya que hoy en día es una parte integral e inevitable de la misma, y es importante que seamos conscientes de nuestro nivel de estrés saludable para prevenir los efectos perjudiciales de un nivel de estrés demasiado alto.
El problema viene cuando este estrés se prolonga en el tiempo, prolongando a sí mismo nuestra respuesta fisiológica de forma continuada, con la consecuente alteración en el equilibrio de las funciones orgánicas y convirtiendo el estrés en crónico ya que la persona no es capaz de hacer frente a esa situación mantenida en el tiempo.
Las causas pueden ser variadas: situaciones laborales, familiares, estudios….. y es la frecuencia de presentación del estresor lo que provoca las consecuencias dañinas para la salud. En ocasiones, no es el evento estresante en sí lo que provoca el estrés, sino cómo interpretamos este evento y cómo lo afrontamos. Lo que para una persona puede ser estresante, para otra no lo es.
Cuando el estrés es continuo en el tiempo, todos nuestros procesos fisiológicos se desestabilizan y empieza a haber problemas, llegando a convertirse en patológico y ocasionando importantes trastornos en el organismo.
La persona con estrés crónico, a diferencia de la que sufre estrés agudo, muchas veces no es consciente de lo que le está ocurriendo, pues se ha acostumbrado a esta situación pese a no haberla superado. En el estrés crónico es posible atenuar algunos efectos sin llegar a eliminarlos a menos que se realice una intervención especializada, sin embargo es posible prevenir estos efectos mediante terapias psicológicas y técnicas de relajación.
articulo completo: https://quiropracticaymas.blogspot.com/2021/05/estres-cronico.html
Quiropráctica y Artrosis
La mayoría de los científicos y clínicos han considerado durante mucho tiempo la artritis como un proceso inevitable, universal, lentamente progresivo y degenerativo que acompaña a los seres humanos a medida que avanzan desde la edad media hasta más tarde en la vida. Mito que se ha invalidado ya que nuevos estudios demuestran que el proceso puede llegar a revertirse.
La artritis tiene una alta prevalencia a nivel mundial e incluye más de 100 tipos, los más comunes son la artritis reumatoide, la osteoartritis, la artritis psoriásica y la artritis inflamatoria. La etiología exacta de la artritis sigue sin estar clara y no existe cura, debido a eso los medicamentos antiinflamatorios que se usan comúnmente en el tratamiento de la artritis están asociados con efectos secundarios importantes y pocas soluciones al problema.
La artritis es la principal causa de discapacidad entre los adultos mayores debido al envejecimiento de la población y al aumento de la prevalencia de factores de riesgo (p. Ej., obesidad, traumas, edad, genética) por lo que jugará un papel importante en la calidad de vida relacionada con la salud, la independencia funcional y la discapacidad de los adultos mayores en las próximas décadas. Una buena alternativa sin efectos secundarios es el cuidado quiropráctico, que mejora la función del cuerpo y permite tener una mayor calidad de vida.
articulo completo: https://quiropracticaymas.blogspot.com/2021/03/quiropractica-y-artrosis.html
Mareos, Vértigo & Quiropráctica
Una de las quejas más comunes y frustrantes de nuestros clientes es el mareo o el vértigo ya que tiene un impacto significativo en sus actividades de la vida diaria. La incidencia de los mareos en la población general varía entre el 20 y el 30% y se ha demostrado que con cada 5 años de edad hay un aumento del 10% en la probabilidad de sufrir de mareos.
El vértigo posicional paroxístico benigno (VPPB), la neuronitis vestibular aguda y la enfermedad de Meniere causan la mayoría de los casos de vértigo; sin embargo se deben considerar otras causas que incluyen enfermedad cerebrovascular, migraña, enfermedad psicológica,esclerosis múltiple y neoplasias intracraneales. Además del vértigo cervicogénico. Conocer las presentaciones clínicas típicas de las diversas causas del vértigo ayuda a hacer esta distinción. La historia y el examen físico (especialmente de la cabeza y el cuello y los sistemas neurológicos, así como pruebas especiales como la maniobra de Dix-Hallpike) proporcionan pistas importantes para definir el tipo de vértigo. Una vez que se determina que un cliente tiene vértigo, la siguiente tarea es determinar si tiene una causa periférica o central de vértigo para ver si podemos ayudar con los ajustes quiroprácticos o no.
La quiropráctica puede ayudar a reducir las molestias ocasionadas especialmente por el vértigo cervicogénico y VPPB, y ser una gran alternativa a medicación o cirugías que no siempre funcionan y son técnicas más agresivas.
el articulo entero aquí: https://quiropracticaymas.blogspot.com/2021/02/una-de-las-quejas-mas-comunes-y.html
Prevención de Lesiones en Deportes de Invierno
Los deportes de invierno engloban todas las modalidades que tienen lugar en la nieve o el frío. Aunque actualmente también se pueden practicar en instalaciones cubiertas y adaptadas durante todo el año.
Hay muchos tipos de deportes de invierno: esquí, patinaje sobre hielo, snowboard, trineo, motos de nieve, hockey sobre hielo, curling….. pero los más practicados son sin duda el esquí, con más de 200 millones de personas en todo el mundo, y el snowboard.
Con la llegada del invierno, muchas personas se lanzan a practicar estos deportes sin pensárselo dos veces, lo que provoca que muchos lo hagan sin las medidas de prevención adecuadas y sin estar en un buen estado físico, imprescindible junto con una buena técnica para evitar lesiones y practicar de forma segura.
Las lesiones generalmente involucran traumatismos de alta energía asociadas con traumatismos espinales graves. Afectan más frecuentemente a hombres jóvenes y más en snowboard que en esquiadores. Otra de las lesiones más habituales por colisiones a alta velocidad son las lesiones en la cabeza, que van desde un traumatismo menor aparentemente intrascendente hasta una patología intracraneal que pone en peligro la vida. Además de lesiones más leves como esguinces y fracturas de rodilla, tobillo,muñeca o dedos.
Los expertos aseguran que la probabilidad de lesión, en el caso del esquí, es de 2,6 a 3,9 lesiones en 1.000 esquiadores al día.
A pesar de la conciencia del aumento de las tasas y los riesgos de lesiones de la columna en los deportes de invierno alpinos, ha habido poco éxito en la prevención de estas.
Lee el articulo completo aquí: https://quiropracticaymas.blogspot.com/2021/02/prevencion-de-lesiones-en-deportes-de.html
Cómo mantener una buena Postura
La postura es la posición que tiene tu cuerpo mientras estás de pie, sentado o tumbado. La buena postura es tener el alineamiento correcto de las partes de tu cuerpo, mantenido por la tensión adecuada de los músculos contra la gravedad. Sin postura ni tono muscular, nos caeríamos al suelo.
La postura correcta te ayuda a estar de pie, a caminar, a estar sentado y tumbado en posiciones que ponen tensiones mínimas en los músculos y ligamentos durante nuestras actividades.
Una mala postura puede llevar a demasiadas tensiones en los músculos posturales y puede forzarlos a dejar de tensarse.
En el artículo, te contestamos a las siguientes preguntas:
¿Cómo sentarme bien?
¿Cómo estar correctamente de pie?
¿Cuál es la buena postura en la cama?
¿Puedo corregir mi postura? Sí. No obstante, recuerda que problemas posturales antiguos van a necesitar más tiempo para corregirse.
Tu quiropráctico te puede ayudar y aconsejar.
Lee el articulo entero aquí: https://quiropracticaymas.blogspot.com/2020/12/como-mantener-una-buena-postura.html
Cuidado de Mantenimiento
Este articulo estudió el cuidado de mantenimiento quiropráctico para el dolor lumbar.
Demostró ser más efectivo para el paciente que un cuidado puntual/sintomático.
Los pacientes que más se benefician del cuidado de mantenimiento son aquellos que respondieron bien al cuidado inicial, y que se presentaron con dolor intenso, interferencia marcada con las actividades diarias y angustia acerca del dolor.
https://chiromt.biomedcentral.com/articles/10.1186/s12998-020-00309-6
Lesiones en el fútbol y su prevención
El fútbol es el deporte más popular del mundo al que además de equipos profesionales juegan millones de aficionados. Muchos estudios han demostrado que tiene una alta tasa de lesiones que producen disminución de la actividad física y tiempo de trabajo perdido, además de considerables gastos médicos y suelen aumentar en frecuencia a medida que aumenta la edad del participante en el juego.
Estudios epidemiológicos muestran que las lesiones musculares representan más del 30% de las lesiones del fútbol, predominando lesiones agudas y leves.
La mayoría de estas lesiones se localizan en las extremidades inferiores que incluyen la cadera, la ingle, la parte superior de la pierna y la rodilla, la parte inferior de la pierna, el tobillo y el pie. Las más frecuentes y comunes observadas son los esguinces de tobillo y de pie, así como distensiones musculares y las contusiones. Las contusiones y distensiones ocurren en el 90% de todos los casos de afectación muscular.
La mayoría de lesiones son de poca importancia.
Las lesiones se extienden por todas las posiciones de juego y aunque sí hay diferencias entre jugadores profesionales y jugadores aficionados durante la competición, no se observan diferencias en esos grupos durante el entrenamiento.
Hay evidencias que programas de prevención multimodal reducen las lesiones.
Articulo completo: https://quiropracticaymas.blogspot.com/2020/11/lesiones-en-el-futbol-y-su-prevencion.html
Estenosis de Canal
¿Qué es la Estenosis?
Es el estrechamiento del canal vertebral por donde pasa la médula.
La estenosis a menudo es una condición degenerativa. Puede existir durante años sin producir ni dolor ni molestias, pero una caída o un accidente pueden desencadenar el dolor de estenosis.
Existen otras condiciones que pueden mimar una estenosis - hernias discales, claudicación vascular, etc.
La estenosis puede ser diagnosticada con el histórico de síntomas, un examen e imagen.
Signos & Síntomas de la Estenosis
Pseudoclaudicación: dolor producido al caminar o después de mucho tiempo de pie, generalmente aliviado estando sentado e inclinado hacia delante.
Entumecimiento, hormigueo, sensaciones frías/calientes en las piernas.
Pérdida de fuerza muscular y espasmos en las piernas.
¿Cómo se trata la Estenosis?
Existen 3 acercamientos básicos de la estenosis:
Conservador médico – reposo, analgésicos, calor y relajantes
Conservador quiropráctico – ajustes, consejos ergonómicos y ejercicios para hacer en casa
Cirugía.
A menudo el tipo de estenosis dictamina el tratamiento más adecuado.
Articulo completo aquí: https://quiropracticaymas.blogspot.com/2020/10/estenosis-del-canal-lumbar.html
Mochila & Dolor de Espalda
Un nuevo fenómeno preocupante es que los niños están empezando a sufrir dolor de espalda mucho antes que las generaciones anteriores.
Uno de los factores es el uso de mochilas demasiado pesadas, y formas incorrectas de llevarlas.
Puedes hacer algo al respeto:
Asegúrate de que la mochila no pese más del 10% del peso corporal de tu hij@.
Haz que tu hij@ lleve la mochila con las dos asas.
Si sigue pesando demasiado, habla con el profe de tu hij@ para ver cómo podría llevar menos peso entre casa y el colegio.
Si tu hij@ tiene dolor o molestias por usar la mochila, llámanos.
Los quiroprácticos tienen una formación adecuada para cuidar de personas de todas las edades, con un cuidado particularmente suave para los niños.
Además, los quiroprácticos pueden recomendarte ejercicios para ayudar a tu hijo a fortalecer su espalda, así como consejos de alimentación, posturas y sueño correctos.
Lee el articulo completo aquí: https://quiropracticaymas.blogspot.com/2020/09/mochila-dolor-de-espalda.html
Ergonomía para prevenir lesiones
La ergonomía es una ciencia interdisciplinaria que estudia las relaciones entre el hombre y su puesto de trabajo. Una mala planificación del trabajo desde el punto de vista ergonómico produce fatiga, desmotivación, pérdida de concentración, disminución del rendimiento…
Los principales factores de riesgo ergonómico físico están relacionados con los sobreesfuerzos, los movimientos repetitivos y las posturas inadecuadas que derivan sobre todo en trastornos músculo esqueléticos, uno de los problemas más comunes relacionados con las bajas laborales.
Para evitar todo eso debemos conocer cómo mejorar nuestras posturas y nuestro entorno de trabajo o estudio para intentar minimizar el daño físico y mental.
La investigación ha identificado 5 factores principales asociados con molestias musculoesqueléticas:
Falta de selección de trabajadores y falta de formación adecuada para prevenir riesgos laborales
Diseño ergonómico deficiente del lugar de trabajo y la tarea
Posturas de trabajo deficientes
Falta de variación de las tareas
Pausas de descanso insuficientes
Estos factores podrían mejorarse introduciendo intervenciones ergonómicas tanto para ajustar los lugares de trabajo individuales como para la tarea realizada. Es necesario considerar medidas preventivas que deberían incluir:
Consideración de la selección adecuada de trabajadores para diversos trabajos con suficiente formación e instrucción
Rediseño ergonómico de los lugares de trabajo
Consideraciones ergonómicas en la organización de trabajo.
Si necesitas más información sobre ergonomía, quieres revisar tus hábitos posturales y corregirlos si es necesario puedes contactarnos.
El articulo completo: https://quiropracticaymas.blogspot.com/2020/09/ergonomia-para-prevenir-lesiones.html
Discos Intervertebrales
Los discos son una parte muy importante de tu columna - amortiguan los impactos, protegen la médula espinal y permiten la flexibilidad de la columna...
Los problemas discales más comunes son:
Abombamiento, Protrusión y Hernia discal
Degeneración discal
Los discos nunca se desplazan. Envejecen, se abomban, algunas veces se hernian, y a veces comprimen un nervio o liberan sustancias químicas que lo irritan. Los discos cicatrizan, pero lo hacen de forma lenta y muchas veces incompleta.
Hay poca correlación entre la degeneración del disco y la sintomatología y/o el pronóstico.
Cuando un disco sufre una lesión, puede que no duela enseguida, sino que aparezca entre 8 y 12 horas después, a medida que el disco se inflama. A menudo, una lesión del disco producirá dolor (cuello o lumbar - brazos o piernas si irrita las raíces nerviosas) y rigidez al día siguiente de la lesión.
El diagnóstico requiere un historial y examen completo.
Las radiografías pueden ser útiles pero sólo en ciertos problemas.
La resonancia es el mejor examen para ver el estado de los discos, pero no suele ser necesario.
La mayoría de los casos de problemas discales pueden ser tratados con métodos conservadores.
Es importante volver a tus actividades de forma segura lo antes posible.
Los ajustes quiroprácticos también han mostrado ser una herramienta segura y efectiva en la gestión de problemas discales.
En la mayoría de los casos, la cirugía o las infiltraciones no son necesarias y se reservan para casos serios o que no responden al cuidado conservador.
Si tu (o un conocido) sufres de problemas discales, llamanos para estudiar tu caso y darte opciones de cómo gestionarlos.
Quiropráctica & Niños
Cada vez hay más evidencia de que la salud y el estilo de vida en la infancia pueden tener un impacto en la salud y calidad de vida en la adultez. La atención quiropráctica puede ayudar a mejorar esa calidad de vida desde la infancia de una forma segura, lo que incluye, no solo manipulación espinal, sino también consejos nutricionales, corrección de la postura o prescripción de ejercicio físico.
El articulo entero aquí: https://quiropracticaymas.blogspot.com/2020/08/quiropractica-segura-desde-ninos.html
Artrosis y Neuroinflamación
El dolor resultante de la artrosis proviene de componentes inflamatorios y neuropáticos. Todavía no existe una clara patogénesis de la enfermedad articular, sin embargo, el consenso prevaleciente apoya el diálogo cruzado entre el cartílago y el hueso subcondral. La pérdida de equilibrio entre estas dos estructuras en casos de enfermedad articular (provocado, entre otros, por cargas inapropiadas en las articulaciones) se amplifica por la presencia de mastocitos, cuya desgranulación se asocia con alteraciones de todas las estructuras articulares. Además, la activación persistente de los mastocitos acelera la proliferación de la neuroinflamación espinal.
Actualmente, el tratamiento convencional de patologías reumáticas y articulares se centra en el alivio sintomático con efecto limitado sobre la progresión de la condición...
Las substancias capaces de contrarrestar la progresión de la enfermedad, deberían ser el foco futuro de la investigación. Estos incluyen moléculas que se dirigen a los receptores de cannabinoides (como PEA - palmitoiletanolamida) y PPAR (receptores activados por proliferadores peroxisómicos). Esta investigación podría cambiar el enfoque del tratamiento de la osteoartritis y la artritis reumatoide desde el alivio sintomático hasta el mantenimiento o incluso revertir el daño articular.
PEA está disponible en línea en cápsulas. Se sugiere que la dosis se puede aumentar desde 400 mg hasta 1200 mg por día de forma gradual.
Es una opción en caso de querer evitar o limitar el uso de medicamentos...
Referencia: Fusco, Mariella, et al. "Degenerative joint diseases and neuroinflammation." Pain Practice 17.4 (2017): 522-532.
Dolor de Cabeza & Quiropráctica
Si te duele la cabeza, no estás solo. 9 de cada 10 personas padecen dolores de cabeza. Algunos son ocasionales, otros frecuentes; unos sordos, otros agudos, y algunos muy intensos y/o con náusea.
Los dolores de cabeza pueden tener varias causas o desencadenantes.
Incluyen alimentos, estímulos externos (ruidos, luz, estrés...) y/o comportamientos (insomnio, ejercicio excesivo...)
El 5% de los dolores de cabeza son signos de alarma debidos a problemas físicos.
El 95% de los dolores de cabeza son primarios, como la cefalea tensional, la cefalea cervicogenica, la migraña o la cefalea en racimos. Estos dolores de cabeza no son debido a enfermedades, sino que el dolor de cabeza es el problema en sí.
¿En qué te puede ayudar un quiropráctico?
Ajustar tu columna para mejorar su función y aliviar el estrés sobre tu cuerpo.
Darte consejos nutricionales.
Darte consejos posturales, ergonómicos (posición de trabajo), ejercicios y técnicas de relajación. Estos consejos deberían ayudar a evitar la acumulación de tensiones e irritaciones en los músculos de la columna y del cuello.
Investigaciones recientes muestran que los ajustes vertebrales – la principal forma de cuidado quiropráctico – pueden ser una opción efectiva para las cefaleas tensionales, cervicogénicas y migrañas.
Lee el articulo entero aquí: https://quiropracticaymas.blogspot.com/2020/07/dolor-de-cabeza-y-quiropractica.html
Mantente en Forma con el paso de los años
Aunque el ejercicio físico sea bueno para todos, cuando nos hacemos mayores puede que nos resulte más difícil, especialmente a la hora de empezar…
Si has estado inactivo un tiempo, puede que sientas molestias y dolores, pero disminuirán con el tiempo.
Primero, escoge una actividad que te gusta, y hazla regularmente. Haz que el ejercicio sea lo más agradable posible.
Segundo, empieza gradualmente, comenzando con 5 min de ejercicio. A medida que te encuentres más cómodo con la rutina y empieces a notar los beneficios del ejercicio, aumenta el tiempo que le dedicas.
Antes de empezar un programa de ejercicio, consulta a un profesional de salud. Aunque el ejercicio física sea saludable, el tipo de ejercicio podría tener efectos positivos o negativos según tu estado actual de salud.
Haz un plan de ejercicio y síguelo. Incorpora tu plan de ejercicio en tus actividades diarias, o aprovecha tus actividades diarias para mantener sanos tus huesos y músculos.
El mejor programa de ejercicio debería estar diseñado a medida según tu estado de salud. Tu quiropráctico podría ayudar a planificarlo.
Para leer el articulo completo: https://quiropracticaymas.blogspot.com/2020/08/mantente-en-forma-con-el-paso-de-los.html